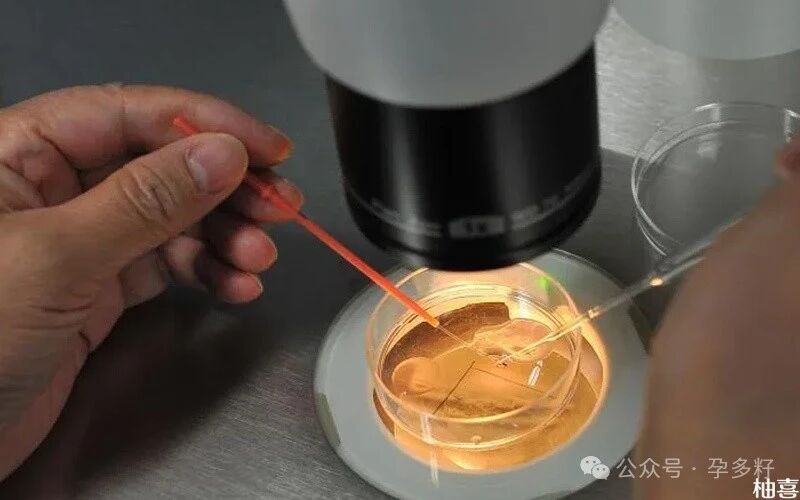

国内海外辅助孕育,高龄夫妻_LGBT人群_HIV洗精_三代试管选xy!
8个胚胎养囊能成几个还要因人而异,因为养囊也并非百分百成功,有的女性养囊8个结果只能养成1个质量差的囊胚,甚至有的女性养囊全部失败,无可移植的胚胎,因此弄清楚胚胎养囊成功率对于考虑养囊的女性来说是很有必要的。
8个胚胎最终能养囊几个
8个胚胎数量还是比较多,因此8个胚胎养囊能够成功3-5个左右,但是这个不是一个准确的数值,也有女性可能会出现养囊全部失败的情况,一般来说,养囊数量一般不与胚胎数量有关,只有胚胎质量越高,养囊成功的几率才会越高。
养囊对胚胎质量要求比较高,而胚胎是由精子和卵子结合而成,因此在胚胎养囊过程当中,会受到精子和卵子质量的直接影响,胚胎质量一般的或者胚胎数目少的,很有可能培育不到囊胚阶段,因此养囊也不会成功,所以8个胚胎养囊最终能成几个还要根据具体情况而定。
Tips:
并且8个胚胎养囊对实验环境也有要求,室内温度、湿度、培养皿的PH酸碱度、渗透压等指标的变化都是影响养囊进度的重要因素,因此养囊数量不可一概而论,8个胚胎养囊成功的几率也是因人而异的,建议女性在养囊前先了解其成功率再说。
8个胚胎养囊成功率剖析
一般来说囊胚培养的成功率在40%-60%左右,所以8个胚胎养囊成功率大概也在这个范围之内,养囊成功率与胚胎数量关系不大,主要取决于精子卵子质量、养囊技术和实验室设备等,所以8个胚胎养囊成功率受影响因素其实有很多,具体成功率也要因人而异。
通常情况下女性年龄越年轻,卵子质量越好,此时胚胎染色体的问题就较少,取出8个胚胎继续培养形成囊胚的比例就较高,此外也与男性的精子质量有关,如精子密度、活动度,以及精子的DNA碎片率等,均可能会对养囊成功率产生影响。
Tips:
总之,8个胚胎养囊成功率高低每个人都是不一样的,而且养囊存在一定的风险,囊胚在体外的培养时间不同,对营养的需求量也会有不同,这与医生的专业程度也有一定的关系,因此更加考验医生和技术人员水平的稳定性,建议最好在医生的专业指导下进行胚胎养囊,然后根据自身的情况而视,在选择养囊的时候要慎重虑。